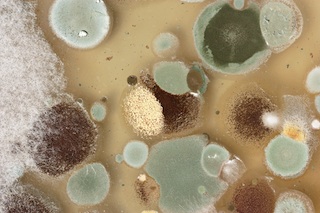

Breathe Deep! How to Improve Your Indoor Air Quality

The Environmental Protection Agency (EPA) considers poor indoor air quality the fourth-greatest pollution threat to Americans. Whether in a bucolic spot like the Hamptons or a big city like New York, people spend the majority of their time inside their homes. Small children spend even more time inside their homes, and many doctors advise that these children are the most susceptible population to bacteria and disease, since their immune systems are still developing.
The problem has become large enough that recently the EPA published “Version #1 Indoor Air Plus,” which covers building techniques for new construction to minimize indoor air pollution. Unfortunately, this does not help the millions of homes already in existence. What follows, however, are some helpful suggestions for improvement of indoor air quality for existing homes.
Most people just assume that the air we breathe inside our homes is somehow better or healthier than the air outside, which at times can appear hazy or polluted. In reality, “Indoor Air Quality” is simply a combination of polluted air from outside the home combined with air pollution created inside. Due to the vast number of organic and non-organic chemicals that we come across each day, many of these harmful materials are brought in to our home through our shoes, clothing, shopping bags, even our own hair. Additionally, poor air circulation in our homes, especially when windows and doors are closed, creates a potentially harmful situation.
Where Does Indoor Pollution Come From?
Indoor air pollution comes from a combination of non-organic and organic products and chemicals in the home. Everything from furniture to certain plastic products; paint; tobacco products; building materials (especially pressed wood products); products for household cleaning and maintenance, personal care or hobbies; central heating and cooling systems and humidification devices; pesticides; and carpeting and area rugs. A variety of groups including ABC News and Good Morning America have had special shows exposing the dangers of indoor air quality over the last couple of years. An average home has been reported to have well over 100 dangerous pollutants.
How Harmful Is It, Really?
Fortunately, most of the pollutants are in low enough concentration that they are not harmful for most individuals. However, a research study on Microorganisms in Carpet done by Karen K. Leonas, PhD at Georgia State University in 2003, cited several dangerous microorganisms that lead to unhealthy air and potential unhealthy situations. Leonas identified a clear relationship between microorganisms and textiles in the indoor environment.
She stated that “Each indoor environment is unique and is characterized by its own sources. Indoor air is a complex mixture of bio aerosols and non-biological particles. Among the most important of these are human and animal occupants that shed skin scales and other fragments, mold spores, viruses, and bacteria. Any occupied environment will contain these kinds of airborne particles in levels dependent on the activity of the occupants as well as ventilation rates and patterns in the space. House dust is complex and contains non-biological as well as biological components. These components may include dead organisms, skin scales, other arthropod and mammalian effluents, soil, other material tracked in from outdoors, pesticides, cleaning agents, and organisms such as bacteria, fungi and arthropods that use many of these materials for food. Although there are a number of research articles that report on the relationship between indoor allergens and childhood asthma, few of these actually identify carpet or other textile products as a source for these allergens.
How to Improve Indoor Air Quality in Your Home
Rugs and Carpets—A Help or Hindrance? Carpets and area rugs act as an excellent filter to gather dust and remove microorganisms and other hazardous particle from the air. Without these textile soft surfaces, harmful organisms and chemicals would collect on the floor and get kicked up and become airborne as people walk through their homes.
However, just as you must change your AC air filter periodically, routine rug cleaning by professionals is also a necessity. If rugs and carpets are not cleaned regularly, they can be the largest source of microorganisms and lead to amplifying poor indoor air quality. Furthermore, carpets and rugs must be cleaned with proper organic and natural organic materials that do not add to the problem.
Further investigation has shown that individuals who are most sensitive are best served by homes with hard-surface floors covered by area rugs. The reason is simple. Carpets have to be steam-cleaned, but the problem is the drying process. Often wall-to-wall carpets take two or more days to fully dry, and the padding underneath the carpet can hold moisture even longer, especially on humid days. This moisture is a breeding ground for bacteria and microorganisms. On the other hand, area rugs can be easily removed from the home and taken to a reputable organic rug company service, where the rugs will be cleaned using organic soaps and fully dried to prevent any microorganism or mold growth. The rugs can then be taken back to the home. Some companies even offer quick service of five days or less.
What Easy Steps Can We Take to Improve Indoor Air Quality?
Before you bring new products into your home, be sure that they are made with low VOCs (Volatile Organic Compounds)
1. Use only organic cleaning materials. Read the labels.
2. Open your windows for 30 minutes at least once per day.
3. If you are in a humid environment, purchase an inexpensive portable dehumidifier.
4. Clean carpets and area rugs at least annually, more often in heavy traffic areas. An easy way to tell if your carpets and rugs need to be cleaned: Does it look dirty, does it smell. Simple.
5. If remodeling, try to shift to hard surfaces such as harwood or stone floors, and cover the floors with area rugs that can be sent out and professionally cleaned by an organic rug cleaning service.
Some Bigger Important Steps for Sensitive Individuals
Extra measure is often required in challenging environments where there is high humidity, and environments that have high indoor air pollution, especially with small children or adults with severe allergies.
1. Some very exciting new air-filtration technology has been introduced by companies such as American Standard, with their AccuClean™ Whole-Home Air Filtration System. This product removes up to 99.98 percent of allergens from the filtered air, catches particles down to 0.1 micron in size, eight times more effective than the best HEPA room appliance, and 100 times more effective than a standard one-inch throwaway filter or ionic-type room appliance.
2. Clean rugs and carpets at least twice a year.
3. Remove or minimize wall-to-wall carpeting. Area rugs offer the same comfort, act like an air filter, and can be deep cleaned. A variety of natural materials are available both in handmade and machine-made rugs. Avoid hand-tufted rugs, as they have latex glue as a part of their construction. If you have chemical sensitivities, have your new rugs washed prior to use to ensure impurities are removed. Contact a reputable organic rug cleaning service.

The above information was not meant to be a total solution, but more to make the public aware of the hazards of poor indoor air quality and to offer some essential recommendations: Read the labels of all materials that you bring into your home. Use only organic cleaning supplies. Where possible, use hard surface floors covered by area rugs. Clean the area rugs regularly at least once per year by a reputable organic rug cleaning service. In extreme situation, retrofit your home with specialized air filtration products. If you are about to upgrade or remodel your home, consult architects and designers specializing in LEED and green building practices. A little advance research will show you that there are many choices where comfortable design elements, elegance and healthy design can all be achieved under one roof.
For additional information about improving indoor air quality, organic rug cleaning and more, contact revitaRUGS.com at 855-573-8482 or email hello@revitaRUGS.com.









